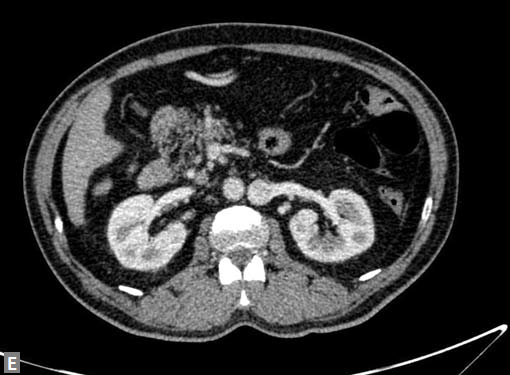

Evidence is the keyword in modern medical practice. Imageological techniques are the major tools in providing evidence. Evidence is needed in confrming the diagnosis and in obtaining the details which substantiate particular method of treatment after the diagnosis of ailment. Evidence is also needed to confrm the outcome after the treatment which may be medical, surgical or percutaneous interventional. It is not uncommon in clinical practice that cross-sectional modalities [multidetector row computed tomography (MDCT), magnetic resonance imaging (MRI), positron emission tomography (PET)] help in arriving at a primary diagnosis when clinical evaluation and echocardiogram alone might not have succeeded. Tere are scenarios where computed tomography (CT) and MRI also unearth the possibilities which were not thought of during clinical evaluation and echocardiogram.
MRI is certainly more versatile than CT and devoid of radiation, but CT continues to play a vital role in routine clinical practice primarily because of its widespread availability, less cumbersome nature of the study and its speed. As modern scanners acquire large volume of data, CT can be more accurately called computed volumetric imaging (CVI).
In this chapter, I have discussed clinical applications of CT in cardiac/cardiovascular diseases.
Sixty-four-slice 1 MDCT is a minimal requirement for cardiac evaluation. Further advanced CT machines acquire images more rapidly and ensure still smoother study. Sixteen-slice CT is not adequate for coronary, cardiac evaluation. Evaluation of left ventricular outfow tract (LVOT), right ventricular
outfow tract (RVOT) and aortic root is not optimal in 16-slice CT, particularly in children.
Availability of ventilators and other lifesaving tools are critical while evaluating children with cardiac compromise particularly those with congenital diseases. Adults generally tolerate the procedure well. However those with congenital heart disease (CHD), marked pulmonary hypertension, right ventricular (RV) and left ventricular (LV) dysfunction need special attention.
Serum creatinine and estimated glomerular fltration rate (eGFR) are the parameters to be considered before contrast administration for the CT.
A stable, controlled, regular heart rate is an absolute prerequisite for coronary evaluation in adults. Lower heart rate is also vital in assessment of coronary anatomy in children.
Smaller size in infants and children necessitates low heart rate and immobility during the study when critical information about aortic root, outfow tracts, cardiac chambers, pulmonary veins are needed.
Beta-blocker like metoprolol is used in adults. Intravenous route is preferred. When beta-blockers are contraindicated, calcium channel blocker like diltiazem is used. Ivabradine can also be used. Ivabradine is a cardiotonic drug and is orally administered. Recommended dose is 5 mg twice daily for couple of days prior to CT.
It is contraindicated in hypersensitivity. It should not be used along with calcium channel blockers. Tis drug can cause arrhythmia, headache, dizziness, blurred vision, nausea, vomiting, constipation, eosinophilia, muscle cramps and muscle weakness. Patients are advised not to drive and operate machinery while taking this medication. It can be stored at room temperature (25°C)
In infants and children, medoxymeditidine infusion is used. Mild sedation to ensure a still baby during the study may be required occasionally. Nitroglycerin (NTG) is not generally used. Beta-blockers and other drugs ensure physiological coronary size without causing vasodilation.
Nonionic, water-soluble contrast like iohexol (each mL containing iohexol 755 mg equivalent to iodine 350 mg) is used as contrast medium. Tromethamine is the bufer and edetate calcium disodium acts as a stabilizer. Contrast medium should be stored at controlled room temperature.
It should be protected from light and secondary radiation and hence not stored in CT gantry room or console.
It is of paramount importance for the radiologist to be aware of present and past medical details of the patient. Some data will have a bearing on technique to be used during CT. For example, if one is aware of the fact that patient has prior coronary bypass surgery with left internal mammary artery (LIMA)-left anterior descending artery (LAD) graft, intravenous access for contrast administration will be chosen from right upper limb. Tis is to avoid artifacts due to contrast fow in upper limb veins obscuring the details of graft if the contrast is given through left upper limb veins. A detailed look at earlier echocardiography, chest X-ray (CXR) will guide the technique of CT to be employed and also diagnostic approach on CT evaluation.
On occasions, these data before a study may obviate the very need of cardiac CT. For instance, occasionally in the practice of cardiac radiology, one may get a request to evaluate an extracardiac mass detected on echo in an infant. A look at the CXR by the radiologist before the CT can suggest an enlarged thymus rather than a mass. A simple radiation-free tool—ultrasound by an expert radiologist is what is needed in this scenario. Discussion with referring doctor is crucial as information available on radiology request form may not be sufcient for the radiologist.
Patient is advised to fast for 6 hours before the study. Smoking, consumption of tea, cofee, chocolate need to be avoided before the study. Patient may be asked to practice breath hold exercise needed for optimal study. If the patient visits the site of CT scanner before the scheduled study, opportunity can be taken to make the patient familiar with the conditions. If the basal heart rate high (more than 65–70 for a 64-slice CT), oral beta-blockers can be advised prior to the CT study.
Faster CT scanners including dual source CT allow the scan to be performed even in wider range of high heart rate. Irregular heart rate as in atrial fbrillation (AF) renders images of inferior quality. In these patients, prospective gating cannot be used.
Prospective gating: Attractive because of associated less radiation2 exposure as compared to retrospective gating. It can be used when heart rate is in the range of 50–60 or lesser. Patient immobility on CT table and regular heart rhythm are all the more important as only one set of images are obtained for interpretation. Functional cardiac assessment is
not possible as data in various cardiac phases are not available. For the same reason, mitral valve prolapse, movement of LA myxoma, or contraction of pseudoaneurysm/diverticulum cannot be demonstrated.
Retrospective gating: 3 After acquisition of the original data, various data sets in diferent phases of cardiac cycle can be obtained. Tis is the technique usually preferred in practice. High radiation is the disadvantage compared to prospective gating. Technique provides reasonable bufer for cardiac motion. What is used is a 3-lead electrocardiogram (ECG). If the hairy chest precludes the placement of leads, the same can be placed on back as well.
Largest possible intravenous cannula should be used. Patency of intravenous access can be confrmed by injecting saline at high pressure. Newer power (pressure) injectors have software which prevents contrast extravasation into soft tissues. Whenever contrast (5–10 mL) escapes inadvertently into soft tissues, the increase in pressure is sensed by the pressure injector and it stops further pumping of contrast. Rate of contrast injection is 5–6 mL/second. Rate can be reduced in patients with smaller built and children. Saline chase is used for coronary evaluation. Saline chase is not given in study for “triple” rule out (Figs 1A to C).
In spite of the best eforts, if the study is suboptimal either because of motion artifacts or faulty techniques, study can be repeated after 24–48 hours. Adequate hydration and premedication with N-acetylcysteine are recommended before the repeat study.
Indications in adults are coronary artery disease (CAD), pulmonary hypertension, mass lesion, aneurysms, CHD, suspected isolated coronary anomalies. Rarely diferentiation between spasm and difuse stenosis may be challenging particularly in left main (coronary artery) (LM). Instead of subjecting the patient to repeat conventional catheter angiogram, CT may be preferred. Patients with low and intermediate risk for CAD, suspected pulmonary embolism (PE) are the two most common indications.
Acute aortic syndrome4 (characteristic aortic pain caused by dissection, intramural hematoma, penetrating aortic ulcer, aneurysmal leak, traumatic transection) is an important indication.
Scenario which warrants a rule out of CAD, PE, aortic dissection CT is the investigation of choice. Tis is known as “triple rule out”. Suspected traumatic injury to great vessels and cardiac chambers is also an indication for urgent CT provided patient is stable enough to be mobilized to CT scanner. Vasculitis of medium and large vessel is a common indication. Peripheral arterial stenosis, aneurysms, traumatic or iatrogenic arteriovenous (AV) fstulas, AV malformations are the other indications. MDCT is also useful in evaluating hemodialysis access fstulas and complications associated with them. Venous stenosis, thrombosis involving pelvic veins, large upper limb veins, inferior vena cava (IVC), superior vena cava (SVC) can be well delineated in CT.
Extracardiac lesions abutting cardiac chambers, tumors
in the vicinity of vessels can be evaluated to depict their
anatomical relations with critical vascular pedicle or heart
itself. Tis provides extremely useful preoperative road map.
Evaluation of vascular stent is another indication particularly
when larger vessel or proximal part of a vessel is the ones to
be interrogated.
Venous grafts, arterial grafts and polytetrafuoroethylene
(PTFE) grafts can be convincingly assessed by MDCT.
Atypical angina, equivocal treadmill can be approached with the help of MDCT. Patients who have mild or moderate risk are the ideal candidates for CT coronary angiogram. Patients with high risk, proven ischemia are directly evaluated by conventional catheter angiogram. As the frst part of the angiogram, a plain (Fig. 2A) study is done. If this reveals excessive mural calcifcation5 in the vessels study can be discontinued as interpretation becomes suboptimal due to artifacts. Although magic number of less than 400 on Agatston scoring is suggested in literature as a cutof to carry out CT angiogram, it is well known that more than the number it is the distribution of calcium which is important. For instance, in the total calcium score of 300, if 250 is in one particular vessel, here evaluation of that particular segment would be extremely difcult. In another scenario where vessels are ectatic, if the distribution of calcifcation is eccentric (Fig. 2B) CT angiogram can be carried out successfully even though the calcium score is high. Tese peripheral calcifcations do not throw much artifacts in the lumen. One needs to be careful in excluding pericardial, mitral annular calcifcation while
estimating the calcium burden. Tis erroneous calcium score may deny a CT
angiogram for one, who otherwise
would have been eligible for the same. Rarely patients who
have established coronary disease and have been advised
catheter angiogram come to CT. Tese patients fnd CT
more acceptable than a catheter angiogram, which they fnd
invasive and not willing to undergo the same.
Motion artifacts6 (Fig. 3) and blooming artifacts due to
calcifcation are the major ofenders in interpretation.
Coronary stenosis (Fig. 4) can be detected efectively.
Degree of stenosis is categorized as minimal, mild, moderate
and marked. Diagnostic accuracy falls as one goes down


to distal part of vessel as caliber decreases. Ostial stenosis
LM and right coronary artery (RCA) can be picked. Rarely
detection of ostial lesion may be the sole purpose of CT, after
an inadequate evaluation of ostia on catheter angiogram.
Even in CT, evaluation of ostial lesion is hard as compared
to diagnosis of segmental stenosis.
The major strength of CT over catheter angiogram is its
ability to image vessel wall (Fig. 5).
The extent of calcification in plaque can be described. The
angulation of the plaque with vessel wall can be judged.


Positive remodeling,7 an independent risk factor pointing
fatal event, is well demonstrated on CT.
Incidental coronary artery variants like ‘J’-shaped proximal
RCA can be brought to the notice before catheterization.
Occasionally “not able to hook” during the catheter angiogram
is one of the indications for CT (Fig. 6).
An unusual cause of ischemia is interarterial (so-called
malignant variety) RCA. Demonstration of origin and course
of this vessel is quite easy on CT although the compromise of
lumen is not consistently demonstrated (Figs 7A and B).
Coronary artery dissection is a rare finding on CT.
Incidental coronary artery aneurysms are seen.
Most common cause is atherosclerotic. Atherosclerotic
aneurysms (Fig. 8A) are generally multiple.
Kawasaki disease is another cause for coronary artery
aneurysm.
In the same sitting, ascending aorta can be assessed for
significant calcified plaques (Fig. 8B). This is an important
finding when coronary artery bypass graft (CABG) is
contemplated. Similarly, whenever required LIMA and right
internal mammary artery (RIMA) can be assessed in the same
sitting.
CT is the preferred tool of investigation of coronary bypass grafts (Fig. 9). Reversed saphenous vein grafts (SVGs) are optimally studied consistently. Anastomotic sites are studied effectively. However, distal anastomosis of venous graft to obtuse marginal branch (OM) is relatively difficult to evaluate because of diminishing caliber of native vessel. Arterial grafts pose a small challenge due to artifacts of associated surgical clips (Figs 10A and B). Ostium and proximal part of graft are assessed well. However, distal anastomotic site may be difficult to assess on occasions. RIMA graft, posterior descending artery (PDA) graft, gastroepiploic artery graft can also be studied. Stenosed venous grafts
can be stented and the same can be evaluated by CT (Fig. 11). Like native RCA, RCA grafts (Figs 12A and B) are more susceptible to motion artifacts when compared to LAD and OM grafts. Catheter angiogram can be used to answer specific queries after CT angiogram.
Most commonly involved vessel is LAD. Proximal and mid segment are affected. Classified into superficial and deep types. OM is the second most commonly involved vessel. Bridging is a small piece of information surgeon would be happy to know about, before CABG.

Computed tomography is the new gold standard investigation
in PE however in most of the cases underlying cause for
pulmonary thromboembolism cannot be made out on
CT. With high prevalence of pulmonary Koch’s in India,
pulmonary thromboembolism is noted to coexist with
chronic pulmonary tuberculosis (Fig. 14).
Pulmonary thromboembolism can be a presenting feature
in renal cell carcinoma, bronchial carcinoma. Rarely HIV
(Fig. 15) can present initially with pulmonary throm boembolism
in which case they can be either bland or septic.
Filling defects (Figs 16A and B) may be seen in main
pulmonary artery (MPA), left pulmonary artery (LPA) and
right pulmonary artery (RPA), interlobar artery, segmental
divisions (Figs 17A and B). On occasions, detection in distal
parts of segmental divisions is difficult. This can be further
confounded by motion artifacts, non- or minimally opacified
accompanying pulmonary veins.
Small lymph nodes in hila can mimic thromboembolism,
particularly in children.
Mural calcification suggests chronicity of thromboembolism.
Bronchial and other systemic collaterals,
dilated MPA (> 28.5 mm) are also indicators of chronicity.
Eccentric filling defect, filling defects only in peripheral parts
of segmental divisions suggest chronicity.
Pulmonary infarcts are generally seen in peripheral
aspects of lungs. These infarcts melt with the treatment of
thromboembolism. Rarely they can cavitate mimicking an
infective process.






Pleural effusion is seen occasionally. Flow related artifacts
mimic thromboembolism, particularly in MPA. In that case, a
delayed scan clears the doubts.
On occasions, thromboembolism can also be seen in right
ventricle and less commonly in pulmonary veins. Systemic
vein thrombus (innominate veins, SVC, IVC) sometimes
accompanies pulmonary thromboembolism (Figs 18A and B).
Very rarely an undetected PDA can throw flow artifacts
mimicking filling defects.
Right ventricular strain is picked up when RV/LV ratio is
more than one with deviation of interventricular septum to
left.
To confirm the resolution of clot in pulmonary vasculature,
CT is repeated after 4–6 weeks of treatment.
Sarcoma9 arising from pulmonary artery is a differential
for chronic pulmonary thromboembolism.
Mass like lesion with striking enhancement of intraluminal
filling defect suggests this diagnosis. Strong index of suspicion
is needed in considering this possibility.
Extensive intima medial hyperplasia of vessels in longstanding
primary pulmonary hypertension and extensive
chronic thromboembolism are difficult to differentiate from
each other.
Lower limb venogram phase of CT is not widely accepted.
Sensitivity and specificity of lower limb venogram assessment
in the same sitting are less. So, Doppler study of lower limbs
has to be judiciously combined with CT in assessment of
patients with PE.
Unexplained breathlessness, patches of consolidation in
CXR, unexplained pleural effusion should be investigated
with CT angiogram to exclude the possibility of pulmonary
thromboembolism.
Mural thickening due to vasculitis should be differentiated
from extensive chronic thrombosis.
Involvement of pulmonary artery in Takayasu arteritis
is almost always accompanied by involvement of aorta and
other systemic vessels. Delayed scans (done after 2–3 minutes
of contrast administration) show mural enhancement
although this particular feature is better appreciated in MRI.
Patches of oligemia is seen in lung parenchyma perfused by
pulmonary arteries which show luminal narrowing due to
mural thickening.
Behçet’s10 disease involves pulmonary arteries. Along with
mural thickening it can cause pulmonary artery aneurysms.
May be associated systemic vein thrombosis including that
of SVC. Lung parenchyma reveals nodules and ground-glass
opacity (GGO) which represent thrombosed pulmonary
arteries and hemorrhage respectively.
It affects peripheral pulmonary arteries causing luminal irregularity and stenosis and resulting in pruned tree appearance. It can be accompanied by aneurysms in pulmonary arteries.
on CXR and CT. Definitive diagnosis in such a scenario can be established by video-assisted thoracoscopic biopsy.
Pulmonary hypertension can occur. Bilateral nodular lesions
are seen. Numerous tiny centrilobular lesions usually
accompany the larger ones.
Pulmonary valve vegetation can be a cause of embolism.
This is particularly so in children who have undergone surgery
involving pulmonary valve and artery like tetralogy of Fallot
(TOF) repair.
Pulmonary thromboembolism can be suspected in
plain CT; however, the diagnosis is made only after contrast
administration. In case iodinated CT contrast cannot be used
due to prevailing clinical scenario, MRI of pulmonary vessels
with or without the gadolinium contrast can supplement
the CT finding in arriving at the diagnosis of PE. On MRI,
thromboembolism involving MPA, RPA and LPA can be
diagnosed. Accuracy decreases for segmental divisions.
Tumor emboli can occur from a right atrial (RA) myxoma.
Computed tomography is an integral part of complete work
up of pulmonary hypertension.
Other than PE which has been discussed above under a
separate heading, there are numerous causes of pulmonary
hypertension. Many of these cannot be suspected or diagnosed
on CXR or echocardiogram. Partial anomalous pulmonary
venous return (Figs 19A to C) is one of them. Sensitivity of
echocardiography for this extracardiac anomaly is less for the
obvious reason. An anomalous vessel can be noted in CXR on
few instances. CT detects number of anomalous pulmonary
veins, their course, presence of vertical and bridging veins.
PDA is one of the most common shunt lesions that could
be missed in echocardiogram.
Connections, caliber, shape and type of PDA can be
evaluated elegantly by radiologist.
Sinus venosus type atrial septal defect (ASD) and unroofed
coronary sinus are lesions that could be looked for by
radiologist, as these lesions are also difficult to visualize in
transthoracic echocardiogram.
Interstitial (infiltrative) lung diseases, emphysema and
bronchiectasis are other causes of pulmonary hypertension.
Rarely complex heterotaxy (Figs 19D to F) syndromes present
as pulmonary hypertension.
Portal system of liver is also evaluated at the same time.
In primary pulmonary hypertension, no obvious cause
can be detected on CT. Vessels are tortuous and ectatic,
particularly in basal segments. Mild bronchiectasis can
develop in long-standing primary pulmonary hypertension
and so being sequela of it rather being the cause. Longstanding
pulmonary hypertension causes bilateral mosaic
pattern in lungs. Unexplained patchy ground glass pattern
should always be assessed with CT pulmonary angiogram.
Aorta11 has five segments namely: (1) root, (2) ascending aorta, (3) proximal aortic arch, (4) distal aortic arch and (5) descending thoracic aorta. Size and shape of aorta vary among individuals and with age in an individual. Aortic root includes annulus, valve and sinuses of Valsalva. Average diameter at the level of sinotubular junction is 36 mm. Ascending aorta extends from sinotubular junction to the level of origin of innominate artery. Average diameter in adult is 35 mm. The aortic arch extends from the origin of right innominate artery to origin of left subclavian artery. Isthmus extends from left subclavian artery to the level of ligamentum arteriosum and is slightly narrower than adjoining descending thoracic aorta, particularly in infants. Most cranial part of descending thoracic aorta is more prominent than rest of descending thoracic aorta and is known as aortic spindle, more commonly appreciated in children. Average luminal caliber of mid thoracic aorta is 25 mm. Distal descending thoracic aorta just above diaphragm has an average of 24 mm.
Connective tissue disease, hypertension and iatrogenic (Figs 19K to L) injury are the common causes for dissection. Radiologist not only establishes the diagnosis, also evaluates the extent of dissection, presence of thrombosis particularly in false lumen. In case of type A dissection, involvement of aortic root is determined. Relation of thrombosed lumen and ostia of coronary vessels, cephalad branches (Figs 19N, R to V) of aorta is determined. Most of the occasions membrane is demonstrated. Spiral nature of the membrane can be seen
by evaluating the aorta in all the three orthogonal planes
(Figs 19O to R).
Tennis ball sign is the classical appearance of dissection on
transverse section.
Double barrel appearance is seen on coronal and sagittal
images. Type B dissections can extend even to common
iliac arteries bilaterally. Superiorly it can extend to involve
common carotid and vertebral arteries.
Second dissection within the true lumen causes “Benz”
sign (Fig. 19J).
Intramural hematoma is a close differential. Presence of
hyperdense substrate in plain study indicates intramural
hematoma. Associated penetrating ulcers can be seen in
descending thoracic aorta and aortic arch.
Sometimes extensive atherosclerotic change with associated
positive remodeling can mimic dissection. However,
absence of membrane and double lumen appearance help to
lean toward the right diagnosis.
Iatrogenic (postcatheterization) dissection usually involves
aortic root. It may have striking appearance when they extend
from femoral artery (point of access for catheterization) to
aortic root.
Motion artifacts12 particularly in aortic root and ascending
aorta can masquerade a dissection.
To avoid these artifacts and make interpretation accurate
retrospective gating should be employed. Pseudolumen
generally enhances late compared to true lumen and
this should not be misinterpreted as thrombus. Delayed
second phase reveals the filling of pseudolumen if it is not
thrombosed. Occlusion of major vessels arising from the
thrombosed pseudolumen can result in ischemia/infarction
of organs/structures supplied by these vessels. Pain in loin
due to renal infarct may be presenting feature of a dissection.
Pericardial effusion may accompany type A dissection.
Hemopericardium is the dreaded complication of leaking
type A dissection (Figs 19S to V). The type B dissection can
cause small foci of atelectasis in adjacent lungs and should
not be mistaken for leak. Type B dissection can leak and cause
left hemothorax.
Any part of aorta can get affected by aneurysms. Focal
dilations can be saccular or fusiform. Atherosclerosis is
the most common cause. Tubercular and other infective
aneurysms, traumatic ones are also uncommonly seen. Size
of the aneurysm, proximity to origin of main vessels, relation
with branching and bifurcation, presence of mural thrombus
are the critical information sought on CT.
Contained leak, rupture are the feared complications.
Aortoenteric fistula is a rare but potentially catastrophic
complication. Aneurysmal dilation is common in ascending
aorta (Figs 19W to Y).
CT is also useful in surveillance of diagnosed aneurysms.

Figs 19A to Y (A to C) Scannogram (A), plain (B) and contrast study (C) show partial anomalous pulmonary venous connection; (D to F) Heterotaxy; (G) Aortic occlusion; (H and I) Aortic stents; (J) Aortic dissection with ‘Benz’ sign due to second dissection within the true lumen; (K, L and M) Aortic dissection with thrombus in pseudolumen following catheter angiogram; (N) Aortic dissection involving common carotid arteries and subclavian artery; (O, P, Q and R) Aortic dissection with right renal artery arising from true lumen and left renal artery from false lumen; (S, T, U and V) Stanford B dissection with extension Y to iliac vessels; (W to Y) Aneurysmal dilation of ascending aorta
Chronic pulmonary hypertension due to ventricular septal defect (VSD), PDA, ASD13 causes pulmonary artery aneurysm. Risk of rupture is highest in those with Eisenmenger’s complex. An iatrogenic cause is TOF repair, i.e. patch aneurysm. Chronic pulmonary thromboembolism, vasculitis as in Hughes-Stovin syndrome, Bechet’s disease (Fig. 20) tuberculosis (Rasmussen) (Figs 21A to H) are the few acquired causes. Behçet’s disease and Hughes-Stovin syndrome are associated with systemic thrombophlebitis. Pneumonia can cause mycotic aneurysm and pseudoaneurysm.14
Carcinoma lung, sarcomatous lung metastasis can cause pseudoaneurysm. Malpositioned Swan-Ganz catheter, chest tubes, surgical resection, biopsy, trauma are the other causes of pseudoaneurysm. Connective tissue diseases like Marfan’s, Ehlers-Danlos syndrome (EDS) and cystic medial necrosis are also the causes even though aorta is more commonly affected.

Mediastinal widening, fracture of first two ribs indicate possible injury to cardiovascular structures. Aortic pseudoaneurysms, dissection, pulmonary artery injury, thrombus formation, myocardial contusions can be seen. Rarely right ventricle can rupture.
Most commonly pseudoaneurysms occur in isthmic region due to “water hammer” effect.
Hemopericardium is a well-known complication of trauma. Pneumopericardium can also occur. Mediastinal hematomas can be noted. Rarely chest trauma can result in pseudoaneurysm of mitral-aortic intervalvular fibrosa. These pseudoaneurysms expand during systole and collapse during diastole which can be demonstrated with acquisition of images in various phases of cycle using data of retrospective gating.
The most common mass lesion in heart is thrombus. Postinfarct clot is common in LV apex. Postinfarct aneurysm of LV may have clot. Rheumatic mitral valve disease with AF has left atrial (LA) appendage thrombus. Large one can extend to body of thrombus. Patients with arrhythmogenic right ventricular dysplasia (ARVD), sarcoidosis can have thrombus in right ventricle. SVC and IVC thrombus can extend to right atrium. Long-standing catheters can be source of thrombus in innominate veins and SVC.
Carcinomas of liver, kidney can directly extend to IVC and then into RA.
Site of the mass and prevailing clinical scenario help to differentiate the clot from neoplasm, although it may not be possible to do the same definitively.
Clots are more likely to have calcific foci (Figs 21I to K) within when they are long standing. Neoplasms with signifi cant neoangiogenesis show discernible contrast enhancement.














This phenomenon is better seen with MRI contrast than with CT contrast. Exceptionally, vascularized throm bus can show contrast enhancement.
Mass lesion in left atrium with ball valve movement is a myxoma (Fig. 21L). Most commonly located near fossa ovalis of interatrial septum (IAS). Multiple myxomas are seen in
Carney’s complex. Calcification may be present. LA myxomas are pedunculated and RA ones are generally sessile.
Tiny soft tissue density lesions in relation to aortic valve represent fibroelastomas. These small lesions cannot be detected many a time and transesophageal echo has better sensitivity. Myxoma can occur in RA and can cause tumor emboli in pulmonary arteries. A fat containing lesion with Hounsfield units ranging in −50 to −100 suggests a lipoma. Lipomatous hypertrophy of IAS can be diagnosed efficiently by radiologist both on CT and MRI. Sarcomas are infiltrative in nature.
More common are metastatic lesions (Fig. 21M). Primary neoplasms can be located in breast, lungs or kidneys. Melanoma is notorious to metastasize extensively including heart.
Follicular carcinoma of thyroid, glomus jugulare can extend to RA through venous structures. Pericardial effusion accompanies many of these metastatic tumors.
Evaluation of extracardiac structures like pulmonary veins, pulmonary arteries, aorta and its branches is often inadequate in transthoracic echocardiography.
CT is the best imaging tool for vascular ring/sling, aortopulmonary (AP) collaterals. CT is a substitute for MRI when latter is contraindicated as in case of pacemakers, surgical implants in the individual.
Usually done under mild sedation and rarely may require general anesthesia for a very short duration. Low- or isoosmolar contrast is used. Contrast with iodine concentration equal or more than 300 mg/mL is used. Generally contrast dose used is 1.5–2 mL/kg body weight, however up to 3 mL/ kg can be used in children safely. Pressure injectors are used ideally; however, hand injection can be practiced with smaller gauge venous cannulas.
ECG-gated acquisition imparts significantly higherradiation dose compared to non-ECG-gated.
Radiologist needs to be aware of echocardiography and CXR findings, past surgical details and findings of catheter angiography in case done prior to CT. For instance, earlier Fontana surgery necessitates simultaneous contrast injection in upper and lower limbs for assessment of Fontan shunt. Delayed scanning may need to be performed in few cases. Timing of image acquisition is a key factor in getting diagnostic quality images. Optimal contrast opacification of vascular structures depends on anatomy, hemodynamic parameters of the child, earlier surgical procedures, age. Timing of acquisition also depends on focus of examination as judged by radiologist. This is achieved by using real-time contrast bolus tracking. In this method, repetitive low-dose
scans are obtained at a same level at a regular time interval of 1–2 seconds, after contrast injection. Data acquisition starts once the threshold reaches an average of 150 HU as measured by the region of interest (ROI) cursor. ROI can be placed on right- or left-sided structure like pulmonary artery or aorta for assessment of right- and left-sided structures respectively.
Only few coronary artery anomalies are hemodynamically significant. Some are called “malignant” as they carry potential risk of sudden cardiac death, particularly in children and young adults. These are ectopic origin of coronary artery from pulmonary artery, single coronary artery, interarterial RCA (Figs 21A to E). Interarterial RCA is the most common malignant form. Retroaortic left circumflex artery (LCX) is the most common coronary anomaly and is not of much clinical relevance. The possible explanations for malignant nature of RCA are compression between aorta and RVOT, particularly during exercise, acute curve, aberrant shape and stenosis of ostium of RCA on left sinus of Valsalva. Retrospectively gated CT is the ideal modality to confirm the diagnosis of malignant RCA.
Very rarely compression of RCA between aorta and RVOT/ MPA can be demonstrated by evaluating the images in various phases of cardiac cycle. More malignant variety is LM arising from right sinus of Valsalva and having interarterial course. More than 30% of these individuals have sudden death. Anomalous Origin of Left Coronary Artery from
This is also known as Bland-White-Garland syndrome. In fetal circulation as pulmonary and systemic pressures are equal, this anomaly is well tolerated in intrauterine life. Most of these die within first year of postnatal life due to coronary steal which results in subendocardial ischemia. Very rarely they go undetected even in adults. This is because of wellestablished collaterals from RCA. Some of these also have stenosis of ectopic ostium which limits the coronary steal and improving the myocardial perfusion. These patients have a risk of sudden cardiac death, particularly during exercise.
It can occur in isolation or in association with persistent truncus arteriosus, pulmonary atresia. It is one of the examples of high-risk anatomy and can turn out a hard medicolegal case for doctor in case diagnosis is missed. They develop symptoms like syncope, angina, myocardial infarcts. Known associations are bicuspid aortic valve, VSD, mitral valve prolapse. Procedural risk during percutaneous coronary intervention (PCI) increases in patients with single coronary artery. Dissection of target vessel can result in catastrophe. Angulation, course of target vessel can pose
challenge during PCI and the same can be tackled better once
they are anticipated.
Lipton-Yamanaka classification of single coronary artery
has been listed in Table 1.
Myocardial bridging is relatively benign intramyocardial
course of coronary vessel, mid LAD being the most common
vessel. However, now it is known that it can cause acute
coronary syndrome, arrhythmia, septal rupture. Interestingly
bridged segment is generally spared in atherosclerosis and
proximal segment is affected more frequently.
After these anomalies of origin, course comes the anomaly
of communication, i.e. fistula. Fistulous communication can
occur with pulmonary artery or cardiac chambers (coronarycameral
fistula) (Figs 22G to I). Radiologist not only confirms
the diagnosis, helps in providing informations before
percutaneous or surgical intervention.
Fibrous type is subannular (submitral, subaortic) and is likely to be due to congenital annular weakness. This type is not usually associated with cardiac or somatic abnormalities. Muscular diverticula are usually apical and are associated with other cardiac anomaly. Muscular diverticula contract in synchrony with ventricular wall.
Classical variety is discrete lesion with shelf-like appearance.
Diffuse variety which involves entire isthmus is called tubular
hypoplasia. Multiple aortic coarctation can occur in Turner’s
syndrome. In severe form of coarctation whole of aortic arch
may be involved (Figs 22C to F).
Imaging features help one choose among surgery, angioplasty
and stenting. Very discrete stenosis can be overlooked
in axial sections and it is vital to evaluate the aorta using
multiplanar reconstruction (MPR), volume rendering (VR)
and maximum intensity projection (MIP) techniques to
buffer the fallacy of individual technique. CT cannot measure
the gradient across the stenosis unlike ultrasound (echo) and
MRI.
Kinking of tortuous aorta without flow obstruction. Distal to kinking may show aneurysmal dilation and hence needs close follow-up to intervene when needed.
Complete absence of a segment of arch. Common association is DiGeorge syndrome.
TABLE 1 Lipton-Yamanaka classification of single coronary artery by site of origin, anatomical course and relationship with major vessels
| Site of origin | Anatomical course | Relationship with major vessels |
| L type | Group I | A (Anterior) |
| Single coronary artery arising from the left sinus of Valsalva | Anomalous coronary artery as a distal portion of other coronary artery | Anomalous coronary artery passes anterior to the pulmonary artery |
| R type | Group II | B (Between) |
| Single coronary artery arising from the right sinus of Valsalva | Anomalous coronary artery that arises from the proximal part of the normally located contralateral coronary artery, then crosses the base of the heart to assume its inherent normal position | Anomalous coronary artery arises from the opposite sinus of Valsalva and passes between the aorta and the pulmonary artery |
| Group III | P (Posterior) | |
| The left anterior descending and circumflex arteries arise separately from the proximal part of the normal right coronary artery | Anomalous coronary artery passes posterior to the aorta | |
| S (Septal) | ||
| Anomalous coronary artery passes through the interventricular septum | ||
| C (Combined) | ||
| Ectopic origin of the left coronary and circumflex artery, with several combinations of course |









Celoria and Patton classification:
Noncomplex associations: LVOT obstruction, VSD, AP window. Complex associations: Taussig-Bing double outlet right ventricle (DORV), persistent truncus arteriosus.
Connective tissue diseases like Marfan’s, EDS can show focal or diffuse aneurysmal dilation and they need to have regular surveillance imaging.
Rare cause of dysphagia due to esophageal compression. It occurs at isthmus with associated aberrant subclavian artery. Vascular ring is not a requisite to cause dysphagia
Laterality of aortic arch, L and D looping of aorta (great vessels) can be convincingly interpreted.
Supravalvular stenosis can occur in isolation or as a component of Williams syndrome. Associated pulmonary artery stenosis is seen in Williams syndrome. Stenosis can also occur at valvar and subvalvar level (Fig. 22B).
Double aortic arch (Fig. 23A) is the most common type and CT easily shows dominant side elegantly and generally thoracotomy is preferred on the nondominant side. Right aortic arch with aberrant left subclavian artery is the second most common type whereas anomalous right subclavian artery with retroesophageal course is relatively common occurence often clinically silent (Fig. 23B).
Computed tomography is not preferred mode of investigation in ostium primum and secundum defects and in fact smaller defects are often missed. Secundum type ASD is the most common congenital heart defect to present in adults. Equalization of contrast density in left and right cardiac chambers during the study is an indication of possible shunt lesion.
Primum type is seen as a defect immediately posterior to atrioventricular valves. Primum variety is associated with Down’s syndrome and other congenital anomalies. This type of ASD is a mild form of endocardial cushion defect. Secundum type is the most common variety. Usually defect is large. Associated RA enlargement, dilation of MPA (Fig. 23G) may be noted. Patent foramen ovale (PFO) and fossa ovalis mimic small secundum ASD. PFO is usually a left to right shunt with a tunnel-like appearance. Events that increase RA pressure such as coughing, Valsalva maneuver, tricuspid regurgitation (TR) can cause right to left shunt in PFO. PFO jet is directed to floor of right atrium and roof of left atrium.
Radiologist has a crucial role in suspecting or confirming the diagnosis in next two types of ASD: (1) sinus venous type and (2) unroofed coronary sinus. Superior sinus venous ASD (Figs 23C to F) represents a defect between SVC-RA junction and LA. It is usually associated with partial anomalous pulmonary venous connection (PAPVC) (right upper lobe pulmonary vein draining into SVC). Inferior sinus venous type has a defect at IVC-RA junction and LA. This too can be associated with PAPVC (right lower lobe pulmonary vein draining into IVC or RA). Unroofed coronary sinus,20 the least
common type of ASD is suspected when contrast escapes from inferior aspect of LA to roof of unopacified coronary sinus. A common association is persistent left superior vena cava (LSVC). Four types of unroofed coronary sinus are described. Type 1 is completely unroofed without persistent LSVC while type 2 is completely unroofed with associated persistent LSVC. Type 3 and 4 are when coronary sinus is partially unroofed in mid and terminal segment respectively.
Stenosis in pulmonary veins21 with normal cardiac connections is very rare. It can affect one to four veins, and range from focal stenosis to atresia. Unilateral obstruction naturally causes less severe symptoms compared to bilateral obstruction. Congenital pulmonary venous obstruction can be considered in cases of recurrent episodes of illness suggesting unilateral pneumonia or edema. Surgical correction of localized stenosis and pneumonectomy are the treatment options. Accompanying features are ipsilateral volume loss in hemithorax, hypoplastic pulmonary artery on ipsilateral side, edema and fibrosis in lung.
In total variety, none of the pulmonary veins has normal connection with LA. In partial variety, at least one of the pulmonary veins drains normally into LA.
All subtypes of total anomalous pulmonary venous connection (TAPVC) namely cardiac, infra- and supracardiac, mixed can be optimally depicted.
Presence of associated anomalies like sinus venous type ASD, LSVC can be demonstrated.
Most common type is partial type where right upper lobe pulmonary vein drains into right SVC. Many of these partial types may go undetected even in adults. Pulmonary venous stenosis can be seen.
The most common SVC related abnormality. It can occur in isolation or in association with other congenital anomaly, latter situation being more common. Usually LSVC drains into coronary sinus and then into RA. When it drains into LA it causes hypoxemia. Presence of bridging (innominate vein) can be noted. This bridging vein may be of significant caliber or stenotic.
As the name itself suggests segment of IVC (hepatic segment) is absent. Significant amount of venous blood is shunted through dilated azygous and hemiazygous system.










Hepatic veins may directly drain into RA or may drain into a common chamber, which in turn drains into RA. It is important to bring interruption to notice of interventionist as it may pose few challenges during catheter-guided procedures.
Pulmonary artery evaluation by echocardiography is inadequate. Even the judgment about presence or absence of pulmonary artery may not be reliable. Occasionally CT can also demonstrate pulmonary arteries not detected during catheter angiography. CT is the tool of choice to establish the presence of pulmonary arteries, their caliber, course (e.g. between trachea and descending thoracic aorta), stenotic focus if any in pulmonary arteries and the presence of confluence of pulmonary arteries. Aortopulmonary
collaterals are efficiently demonstrated including stenosis or aneurysm in these collaterals. Sometimes when these collaterals are large it is difficult to differentiate them from pulmonary arteries and PDA.
In agenesis of lung, ipsilateral pulmonary artery is absent. In hypoplasia of lung, ipsilateral pulmonary artery is of smaller caliber. Interruption of pulmonary artery is usually seen in association with TOF. Usually vessel contralateral to the side of aortic arch is involved. Ipsilateral lung can show areas of bronchiectasis and fibrosis.
Anomalous origin of LPA from RPA and with a course between trachea and descending thoracic aorta. Presentation is due to compression of trachea or due to tracheobronchial stenosis.
Whenever there is no obvious cause of pseudoaneurysm it is taken to be congenital, particularly so in infants. Abscesses mimic pseudoaneurysms as in echocardiograms. However, these can be differentiated by the absence of contrast filling of their cavity and lack of pulsatility. Systolic expansion of pseudoaneurysm can cause compression of adjacent coronary vessel/vessels. Cardiac tamponade is the feared complication.
Diagnosis is established by echocardiogram. Role of radiologist on CT is to delineate the aorta pulmonary collaterals, anomalies of coronary artery (single ostium, anomalous LAD from RCA and traversing anterior to RVOT, LCX from RCA), pulmonary artery interruption, abnormalities of tracheobronchial tree and lung parenchyma.
Patient can have various surgery-related complications. Radiologist has to look for leaks, pulmonary embolism, pleural and pericardial effusion, pneumothorax, pneumopericardium (Fig. 25A), pneumonia, atelectasis, mucus plugs. Postoperative hematoma, infected collection, seromas and pseudoaneurysm can be detected. Cardiovascular structures, lungs, potential spaces are key areas of interrogation by the radiologist. Modified Blalock-Taussig shunt24 (Figs 25B to D) using PTFE graft from subclavian artery to pulmonary is preferred over standard shunt. Shunt diameter is assessed at subclavian artery site, pulmonary artery site, widest site and stenotic site. Source images, MIP, MPR, VR techniques

are used in complete assessment of the shunt and possible complications are looked for. Disadvantages of these asymmetric shunts are unequal flow in RPA and LPA, risk of kinking, stenosis or occlusion. A good alternative is a central (bidirectional) shunt between ascending aorta and MPA or bifurcation of MPA. The advantage of central shunt is symmetric growth of hypoplastic central and hilar pulmonary arteries. Incidence of pulmonary stenosis is reduced.
Growth of pulmonary arteries is assessed by McGoon ratio and Nakata index.
Arterial switch (Jatene) surgery for dextroposition of great vessels can cause stenosis of pulmonary arteries. This is more common on left and is due to juxtaposed ascending aorta as a result of the procedure.
It is useful in assessing coronary arteries after their reimplantation in Jatene arterial switch surgery and after aortic root replacement.
Follow-up of aortic dilation which can occur after TOF repair, Jatene procedure is optimally achieved by CT angiography.
CT is also useful to diagnose restenosis or aneurysm at the site of repair following surgical repair of aortic coarctation or interruption. CT is the modality of choice in investigating stent and associated complications. It is used to confirm patency of stent, to diagnose stenosis, occlusion, thrombus, fracture and stent separation from vessel wall. Residual vessel narrowing and pseudo aneurysm can be diagnosed.
CT is the procedure of choice to assess cavopulmonary shunts (bidirectional Glenn, Fontan, hemi-Fontan).
Pseudoaneurysms at femoral access site, arterial grafts are best assessed by CT (Figs 25E to I).
Internal jugular vein (IJV), subclavian, axillary veins, SVC, IVC, common and external iliac veins can be well assessed by CT by employing appropriate protocols.
IJV thrombus can present as a neck mass and confused with lymph nodes in the absence of strong index of suspicion. Radiologist recognizes the thrombus by soft tissue density filling defects in IJV lumen. Distension of the vein, adjacent stranding are the additional features seen. It is vital to differentiate flow-related artifacts from true thrombus. Delayed scans and experience help radiologists in this regard. To mitigate these artifacts, it is wise to inject the contrast on the side contralateral to suspected thrombus. Most common cause of thrombus is catheter, either indwelling or recent.
Spontaneous thrombus can occur. Extension of glomus jugulare and direct invasion by a thyroidal carcinoma are the other causes of filling defects in IJV. Rarely this systemic vein thrombosis can coexist with pulmonary artery thrombus.
Hemodialysis access fistulas are one of the most common causes of IJV thrombosis. Generally this is associated with thrombosis of other veins like subclavian, axillary. SVC can also get involved rarely. It is advisable to cover SVC-atrial junction, entire RA to exclude the extension of thrombus if any. CT is useful in follow-up of patients who have been treated with venous stents to assess patency of the stent and other complications like leak, stent fracture.
Very rarely aneurysms can occur in IJV. Carotid-IJV fistula can also occur.
Doppler is the initial imageological investigation. However with edema setting in upper limb, CT is more than useful in this situation. Along with fistulous site stenosis, pseudoaneurysm (Fig. 25J) of artery can occur. Rarely venous aneurysm is seen. If a stent graft is used, radiologist assesses it for patency and complication like leak, fracture. In the same sitting, arterial
tree can be assessed. Rarely arterial ischemia can coexist due to accelerated atherosclerotic changes in radial and ulnar artery. It is very common to see mural calcification in ulnar and radial arteries in these patients; however, these calcified lesions rarely cause hemodynamically significant stenosis. Central venous thrombosis is a common complication.
Thrombosis is associated with lower limb veins thrombosis. Occasionally renal vein thrombosis can extend to IVC. In Budd-Chiari syndrome, chronic stenosis of IVC and membrane in IVC are seen.
Along with IVC, relationship of iliac veins and artery is assessed. May-Thurner syndrome occurs when left common iliac vein is compressed between the right common iliac artery and the vertebral body. Reverse May-Thurner syndrome occurs in situs inversus abdominus associated with heterotaxy syndromes.










Aneurysms occur in IVC rarely. Gradman and Steinberg have classified IVC aneurysms25 (Fig. 26) into four types. Type 1 involves suprahepatic IVC and there is no IVC obstruction associated. Type 2 is associated with supra- or infrahepatic caval interruption. Type 3 involves infrarenal IVC and there is no associated congenital anomaly. Type 4 involves iliac veins and usually a left IVC is seen. Like elsewhere, aneurysm can be saccular or fusiform, shape wise.
Leiomyosarcoma is a rare primary tumor which can arise from IVC. Renal cell carcinoma and hepatocellular carcinoma may extend to IVC and reach even RA in contiguity.
An interesting fistula between iliac artery and vein can occur following a lumbar disk surgery. Patient generally presents with unilateral slow onset lower limb swelling and generally a bruit can be heard in lower abdomen/pelvis.
In general assessment of lower limb venous system is not adequate in CT. An AV fistula following a femoral puncture is one common scenario a radiologist comes across. Enhancement of venous structures in early arterial phase including IVC is the first clue. A track between the artery and a vein is generally well seen by the radiologist. Venous malformation is seen as diffuse hypodensity with cystic spaces in soft tissues of upper limb or lower limb. A faint contrast enhancement in delayed scan, characteristic of a low-flow malformation is seen. Enhancement of septa is suggestive of lymphatic malformation and mixed occurrence is not infrequent. In AV malformation, feeder arteries and draining veins are seen. Arteries generally are hypertrophied.
It is constellation of venous and capillary malformation with soft tissue and bone hypertrophy of limb. Persistent lateral marginal vein is an association. CT demonstrates bone hypertrophy with length discrepancy in lower limbs, hypertrophy of subcutaneous fat and muscles. Superficial venous varicosities, hypoplasia, aplasia, stenosis and dilation of deep veins are the accompanying features. Persistent lateral margin vein is the most common type of fetal veins. When the deep veins are dysplastic, extensive varicectomy is not performed.
Computed tomography should be employed in evaluating all complex pediatric congenital cardiac anomalies before surgery or percutaneous intervention. CT is irreplaceable in the evaluation of PE and pulmonary hypertension. CT is very useful in suspected CAD in individuals with low and intermediate risk. Postprocedural monitoring is optimally done by CT. Computed tomography is the modality of choice in assessing aorta and peripheral arteries. Although Doppler ultrasound continues to be the first choice in evaluating venous system, CT helps in answering specific questions.

Radiation exposure particularly in children is a concern to be addressed using ALARA principle. Functional assessment is not possible (e.g. gradient across a stenotic lesion) or suboptimal (cardiac). Motion artifacts and calcification in vessels are spoilsport in interpretation of CT images, as they behave like “poor echo window” (as in echocardiography).
Medicine is a science of uncertainty and an art of probability. —William Osler